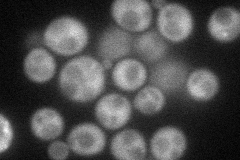
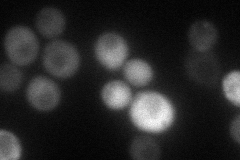
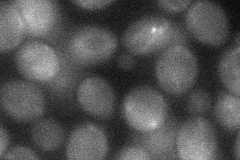
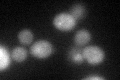
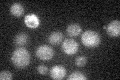

View description
Protein kinase of the Mitotic Exit Network that is localized to the spindle pole bodies at late anaphase; promotes mitotic exit by directly switching on the kinase activity of Dbf2p; required for spindle disassembly after meiosis II
Localization:
Intensity:
Fold change:
Significance:
-
C’ GFP library in SD

punctate20.96 -
N' NOP1pr-GFP in SD
cytosol,punctate57.8676 -
N' TEF2pr-mCherry in SD
cytosol39.8601 -
N' NATIVEpr-GFP in SD

punctate21.379 -
N' TEF2pr-VC and Cyto-VN in SD
cytosol34.0625 -
C’ GFP library in SD+DTT
punctate25.251.2No -
C’ GFP library in SD+H2O2

punctate190.9No -
C’ GFP library in Starvation Media
punctate24.611.17No -
C’ GFP library on the background of Pup2-DaMP

punctate -
C’ GFP library on the background of CCT mutant

punctate19.70070.939311No
